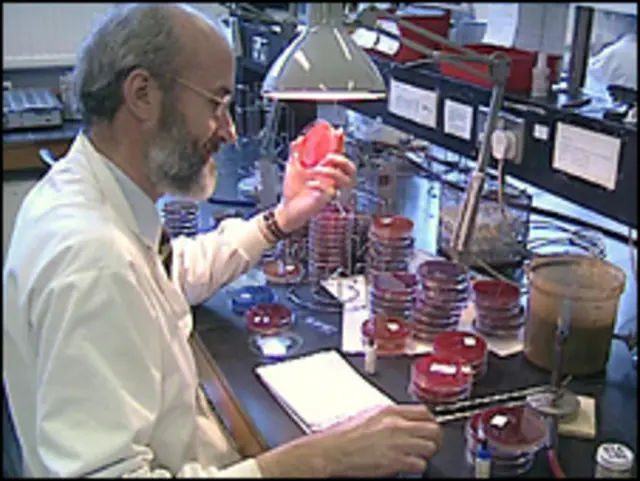
Ученый в лаборатории

Наука и техника по-английски: путеводитель
Друзья, вы находитесь в разделе <link type="page"><caption> Learning English</caption><url href="http://www.bbc.co.uk/russian/learning_english/" platform="highweb"/></link> сайта bbcrussian.com. Здесь мы публикуем учебные материалы и истории о культуре и традициях англоязычных стран.
Наш путеводитель по словечкам из мира науки поможет вам лучше ориентироваться в научной терминологии.
- Nanotech - сокр. от nanotechnology - нанотехнология (область науки, занимающаяся производством материалов и изделий сверхмалых размеров)
- Hi-tech - передовая/инновационная технология
- Hi-definition - досл. высокое разрешение (в сочетании с др.словами: HD TV - high-definition television - телевидение высокой четкости)
- Cyber - кибер (приставка означает нечто относящееся к компьютеру или интернету; пример: cybercafe - интернет-кафе)
- Emissions - выделения, выхлопы или выбросы (газа, тепла или света)
- Test tube - пробирка
- Test tube baby - досл. ребенок из пробирки (родившийся в результате искусственного оплодотворения)
- Bunsen burner - бунзеновская горелка (газовая горелка, названная по имени немецкого химика Бунзена; устройство широко применяется в научных лабораториях для подогрева жидкостей или газов)
- Through trial and error - методом проб и ошибок
- Placebo - плацебо (препарат, которой не имеет физического действия на тот или иной симптом, но по внешнему виду/запаху/вкусу имитирует лекарство)
- A side effect - побочный эффект (от приема мед.препарата; как правило, негативный)
- А miracle drug - чудо-лекарство (так говорят о препарате, с помощью которого можно излечиться от серьезного заболевания)
- Mercurial - ртутный; также: сообразительный или находчивый (о человеке)
- Global warming - глобальное потепление
- Greenhouse gases - газы, вызывающие парниковый эффект (например, двуокись углерода)
- To invent - изобретать
- An inventor - изобретатель
- To discover - открывать, делать открытие, обнаруживать
Также в разделе Learning English
<link type="page"><caption> Тест на знание "умных" технических терминов</caption><url href="http://www.bbc.co.uk/apps/ifl/russian/quizengine?quiz=1131_LE_tech;pagerType=pages;pagerData=1;ContentType=text/html;pagerType=pages;pagerData=1" platform="highweb"/></link>
<link type="page"><caption> Тест "Наука и изобретения" </caption><url href="http://www.bbc.co.uk/apps/ifl/russian/quizengine?quiz=1213_le_science;pagerType=pages;pagerData=1;ContentType=text/html;pagerType=pages;pagerData=1" platform="highweb"/></link>
<bold><link type="page"><caption> <italic>Другие тесты, обучающие видео и аудиопрограммы</italic></caption><url href="http://www.bbc.co.uk/russian/learning_english/2009/04/090414_le_archive_new.shtml" platform="highweb"/></link></bold>
<link type="page"><caption> </caption><url href="http://www.bbc.co.uk/russian/learning_english/2009/04/090414_le_archive_new.shtml" platform="highweb"/></link>














